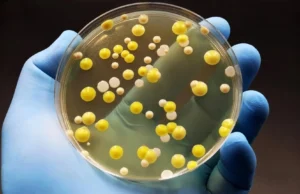
O grafeno mata “superbactérias” bacterianas prejudiciais, mas poupa as células humanas
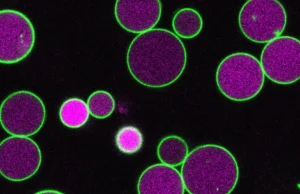
Cientistas acabam de descobrir o que impede as células vegetais de crescerem descontroladamente

Everton Oliveira
Testes de DNA em garrafas revelam surpresas com vermes mezcal
No fundo de algumas garrafas de mezcal está uma das curiosidades mais reconhecidas do mundo das bebidas espirituosas: um "verme" pálido e enrugado preservado...
A tábua de salvação marítima do Panamá desapareceu pela primeira vez...
Todos os anos, durante a estação seca da América Central (geralmente entre dezembro e abril), os fortes ventos alísios do norte ajudam a impulsionar...
A pesquisa de DNA reescreveu as origens da espécie humana
Uma análise genética abrangente está a desafiar uma das versões mais simples da história da origem humana: a ideia de que todos os humanos...
T. Vasos sanguíneos encontrados em ossos de Rex estão reescrevendo a...
Apesar de décadas de esforços, os cientistas não conseguiram recuperar o DNA dos dinossauros. A maior parte da investigação paleontológica hoje centra-se na procura...
Lagartos agressivos “Hulk” estão apagando milhões de anos de evolução
Durante milhões de anos, uma mistura vibrante de cores foi mantida dentro de uma única espécie de lagarto. Agora, grande parte dessa diversidade foi...
Águas mais quentes estão sobrecarregando um agressivo predador de salmão no...
O aumento das temperaturas nos rios do centro-sul do Alasca está causando mudanças visíveis no comportamento dos agressivos lúcios do norte. À medida que...
O grafeno mata “superbactérias” bacterianas prejudiciais, mas poupa as células humanas
A higiene é essencial para itens do dia a dia que entram em contato próximo com o corpo, incluindo roupas, máscaras e escovas de...
O óleo de peixe pode danificar o cérebro, segundo novo estudo
Um novo estudo da Universidade Médica da Carolina do Sul está levantando novas preocupações sobre suplementos de óleo de peixe, especialmente para pessoas que...
Cientistas acabam de descobrir o que impede as células vegetais de...
As plantas usam a fotossíntese para produzir energia durante a maior parte de suas vidas. No entanto, nos estágios iniciais, após uma semente começar...
Insetos pré-históricos gigantes não precisavam de alto oxigênio, segundo estudo
Trezentos milhões de anos atrás, a Terra não se parecia em nada com o que é hoje. Os continentes se uniram em um enorme...